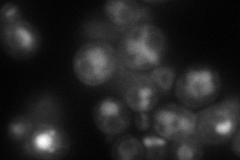
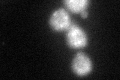

View description
Endosomal protein that interacts with phospholipid flippase Drs2p; interaction with Cdc50p is essential for Drs2p catalytic activity; mutations affect cell polarity and polarized growth; similar to Ynr048wp and Lem3p
Localization:
Intensity:
Fold change:
Significance:
-
C’ GFP library in SD

punctate29.29 -
N' NOP1pr-GFP in SD

ER,punctate82.4156 -
N' TEF2pr-mCherry in SD
ER,vacuole73.2377 -
N' NATIVEpr-GFP in SD

punctate27.1915 -
N' TEF2pr-VC and Cyto-VN in SD

cytosol,punctate34.2465 -
C’ GFP library in SD+DTT
punctate34.431.17No -
C’ GFP library in SD+H2O2

punctate32.591.11No -
C’ GFP library in Starvation Media

punctate44.621.52Yes -
C’ GFP library on the background of Pup2-DaMP

punctate -
C’ GFP library on the background of CCT mutant

punctate35.64731.21662No
